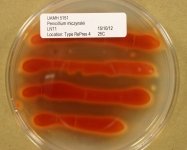

Search Details
| UAMH Number: | 5151 |
|---|---|
| Species Name: | Penicillium miczynskii |
| Type: | Penicillium atrosanguineum |
| Synonyms: | Penicillium sulfureum |
| Taxonomy: | FUNGI Ascomycota, Eurotiomycetes, Eurotiales, Aspergillaceae |
| Strain History: | B.X. Dong -> Pitt, J.I. (FRR 1726) -> UAMH |
| Substrate: | wheat in silo | Location: | CZECH REPUBLIC Prague (GEO: 50.076,14.438) |
| Isolator: | B.X. Dong |
| Isolation Date: | 1971 |
| Date Received: | 1985-09-03 |
| Characters: | PIGMENT red - (Click for publications citing UAMH 5151) |
| Compounds: | |
| Cross Reference: | CBS 380.75 // CCF 1397 // CMI 197488 // FRR 1726 // IAM 13722 // IMI 197488 // JCM 22780 // MUCL 31777 |
| Collections: | Living Strains; Dried Herbarium Material |
| Pathogenic Potential: | Human: no | Animal: no | Plant: no |
| Biosafety Risk Group: | RG1 (check the PHAC ePATHogen Risk Group Database for updates) |
| Regulatory Requirements: | No restrictions for Canadian requesters. International requesters must provide all legally required importation documentation prior to shipment. Plant pathogenicity status may be verified by using the USDA Agricultural Research Service (ARS) Fungal Database |
| MycoBank ID: | 271171 |
| Sequences: | >UAMH05151_JN606590_RNApol2 CAGCGATGCGTTGAGACCAACAGGGAGATCTACTTGAATATGGGTATCAAGGCCGCCACCCTGACAAGTGGTCTGAAGTACGCCCTAGCAACGGGTAACTGGGGCGAGCAGAAGAAGGCGGCCAGCGCCAAGGCCGGTGTGTCTCAAGTGCTGAGTCGATACACTTATGCCTCAACCTTATCCCATTTGCGCCGTACCAACACACCCATTGGCAGAGATGGAAAGATCGCCAAGCCGCGACAGCTTCACAACACCCACTGGGGTCTTGTGTGCCCTGCTGAAACTCCTGAAGGTCAAGCTTGTGGTCTTGTCAAGAACTTGGCACTCATGTGCTACATTACCGTGGGTACGCCCAGCGAGCCCATCATCGACTTCATGATCCAGCGTAACATGGAGGTCCTCGAAGAGTTTGAGCCTCAAGTTACACCCAACGCTACCAAGGTCTTCGTCAATGGTGTCTGGGTTGGTATTCATCGCGATCCGTCGCATCTTGTCACCACCATGATGTCCCTGCGCCGACGAAACATGATCTCTCACGAGGTCAGCTTGGTCCGTGATATTCGTGACCGAGAGTTCAAGATTTTCACGGATACTGGTCGTGTGTGTCGACCTCTTTTCACTATTGACAACGACCCCAAGAGTGAGAATGCTGGATCCTTGGTTCTCAACAAGGAGCACATTCGAAAGCTCGAGCAGGACAAAGAATTGCCTGCAAACATGGATGCGGAAGACCGCCGGGAGCGCTATTTCGGATGGGAGGGTTTGGTACGATCCGGAGCTGTGGAGTTGGTGGATGCCGAGGAAGAAGAGACTATTATGATTGTCATGACGCCTGAAGACTTGGAAATCTCCAAGCAGCTCCAGGCCGGCTACGCGCTGCCAGAGACTGATTCGGATGACCCCAATAAGCGAGTC |
IMAGES: